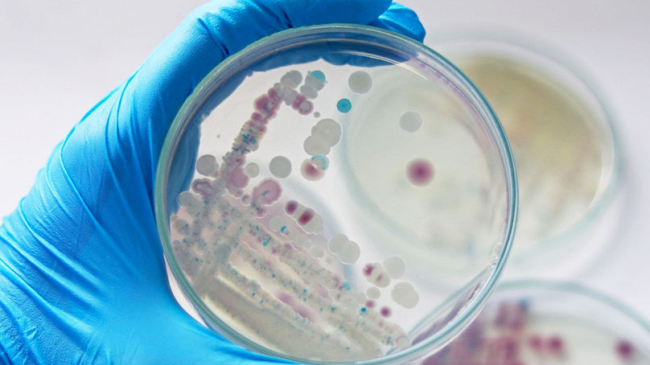
mamaplus

Pentru prima dată în Chile, oamenii de știință au detectat prezența bacteriilor rezistente la ultimele linii de antibiotice în apele reziduale. Tulpinile care produc carbapenemază de tip KPC au fost identificate în probele colectate din stațiile de epurare din zona Greater Concepción, unde locuiește aproape un milion de persoane.

Lucrarea face parte din teza de master a lui Franco Ilabaca și a fost realizată sub coordonarea profesorului de la Universitatea din Concepción, Gerardo González-Rocha, în colaborare cu Institutul MELISA și alte centre științifice, transmite point.md.
Cercetătorii și-au propus să verifice dacă mecanismele de rezistență la antibiotice depășesc mediul clinic și circulă și în mediul urban. Din 205 izolate identificate, trei s-au dovedit a fi producătoare ale enzimei KPC. Printre acestea se numără Klebsiella pasteurii, Klebsiella pneumoniae subsp. pneumoniae și Citrobacter freundii sensu stricto. Toate tulpinile prezentau rezistență multiplă și purtau gena blaKPC-2. Analiza genomică a arătat prezența unor plasmide responsabile de răspândirea rezistenței, precum și a unor integroni care sporesc capacitatea bacteriilor de a dobândi noi gene. Două dintre culturile analizate aveau similarități genetice cu mostre descoperite anterior în Asia și Europa, ceea ce sugerează o posibilă origine „importată”.
Potrivit lui González-Rocha, aceste descoperiri subliniază necesitatea unei abordări „O singură sănătate”, care să integreze medicina umană, veterinară și ecologică: „Rezistența la antibiotice nu este doar o problemă a spitalelor, urmele ei le găsim și în apele uzate”, a precizat acesta.
Deși procentul tulpinilor identificate a fost scăzut (aproximativ 1,5%), cercetătorii consideră rezultatele un semnal de alarmă. Identificarea timpurie ajută la evaluarea potențialelor riscuri pentru sănătatea publică și la elaborarea din timp a măsurilor preventive.
Președintele Institutului MELISA, Elard Koch, a subliniat importanța cooperării internaționale: „Astfel de proiecte nu doar că sprijină progresul științei, dar ajută și la explicarea către societate a motivului pentru care rezistența la antibiotice este o amenințare globală ce necesită un răspuns comun”.